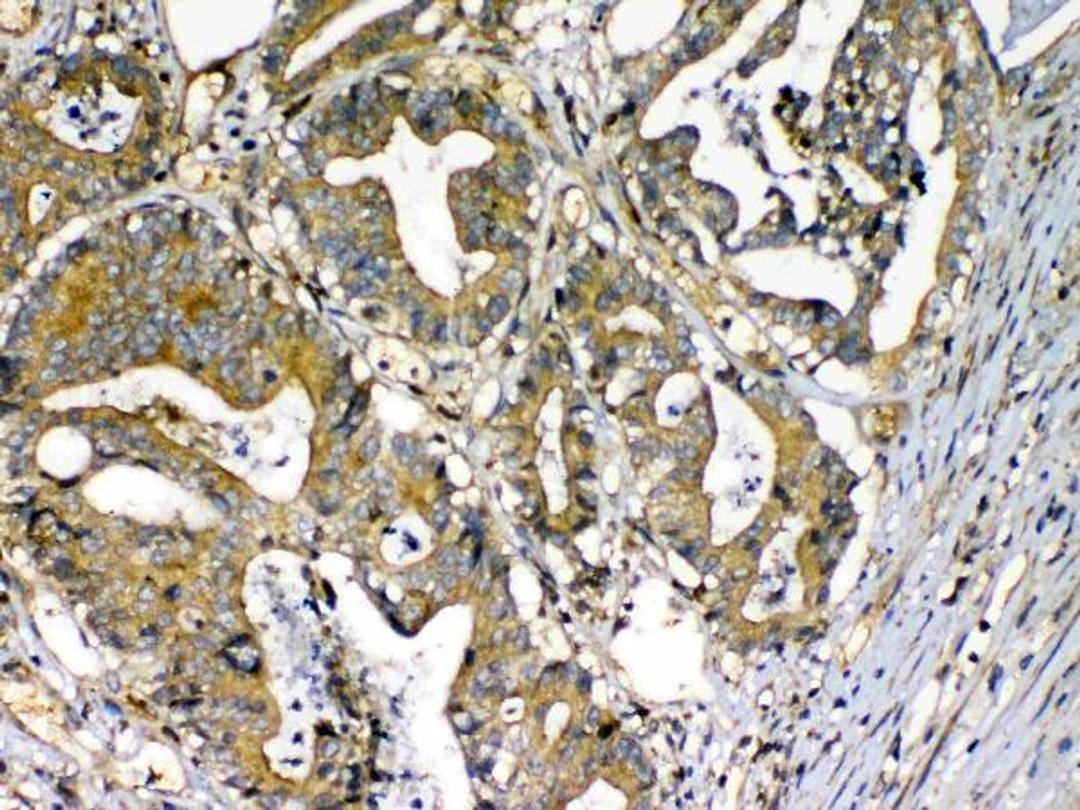

Product & ReviewsAntibodies
Anti-Factor D/CFD Antibody Picoband™
Product Details
- Cat. No.
- A01134-1
- Type
- Primary Antibody
- Clonality
- Polyclonal
- Host
- Rabbit

The supplier does not provide quotations for this antibody through SelectScience. You can search for similar antibodies in our Antibody Directory.
Description
Boster Bio Anti-Factor D/CFD Antibody Picoband™ catalog # A01134-1. Tested in ELISA, IHC, WB applications. This antibody reacts with Human, Mouse, Rat.
Biological Information
- Clonality: Polyclonal
- Host: Rabbit
Handling
- Storage: Store at -20˚C for one year from date of receipt. After reconstitution, at 4˚C for one month. It can also be aliquotted and stored frozen at -20˚C for six months. Avoid repeated freeze-thaw cycles.